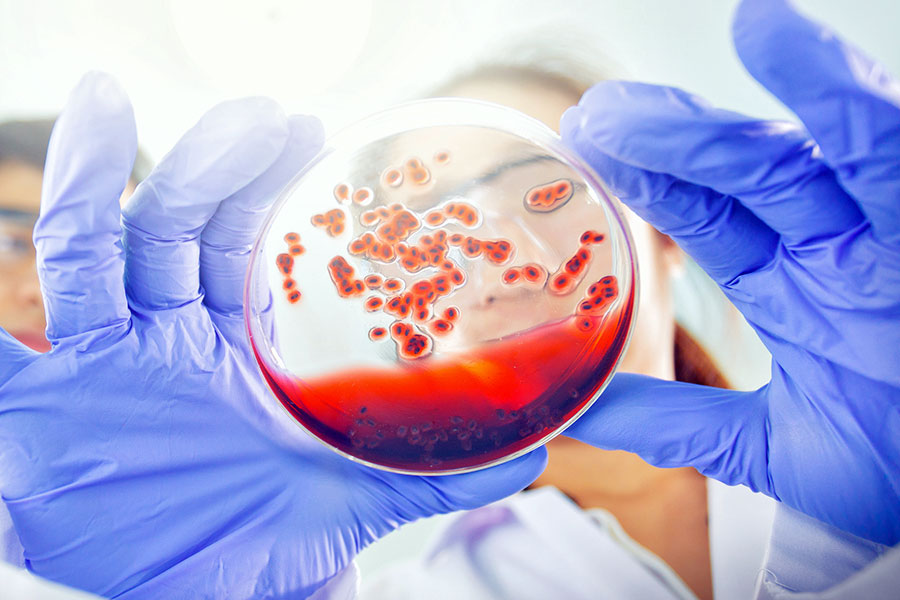
VIHCUERPOTEXTO

Una infección de transmisión sexual, o ITS, no significa el fin de la vida sexual, sino el llamado a llevarla de una forma más responsable.
De la relación sexual a la ITS
Es frecuente confundir una Infección de Transmisión Sexual (ITS) con una Enfermedad de Transmisión Sexual (ETS). Y no son términos equivalentes. Podemos hablar de una ITS cuando una bacteria, un virus o un germen se aloja en el aparato genital femenino o masculino y genera cambios en él. Y de una ETS cuando estos cambios comprometen el aparato genital y también otros tejidos. Una ETS es el estado siguiente de una ITS no tratada a tiempo.
Así lo explica el doctor Juan Carlos Vargas, director científico de Profamilia. Y comenta que esa bacteria, virus o germen normalmente llega al organismo del nuevo portador a través de una relación sexual —vaginal, anal u oral— sin protección con alguien que era portador. Cuando la infección está en el organismo puede manifestarse mediante ciertos síntomas y, según esto, es posible identificar la infección. Las más frecuentes en Colombia son VPH, tricomoniasis, gonorrea y herpes genital.
De la ITS a la relación sexual
Todas las infecciones tienen un periodo de latencia que puede durar semanas, meses e incluso años, según cuál sea la infección y según el sistema inmunológico de cada persona. Sin embargo, cuando la infección supera el periodo de latencia evoluciona a enfermedad. La gonorrea en una mujer, por ejemplo, comienza con flujo, y de la vagina pasa al cuello uterino, de ahí al endometrio, luego a la trompa, sigue al ovario, luego al peritoneo pélvico y al peritoneo abdominal y finalmente al hígado. En el hombre la gonorrea también asciende por el tracto genital y puede producir infección en el hígado y hasta en las articulaciones.
Es fundamental ir al médico al ver o sentir síntomas. Casi todas las ITS pueden controlarse o curarse con tratamientos basados en antibióticos o antivirales. Amparo Ramírez, ginecóloga y obstetra adscrita a Colsanitas, también recomienda asistir a controles anuales para descartar ITS asintomáticas.
Según la especialista, la consulta consistirá en un examen físico y algunos exámenes de laboratorio para confirmar o descartar la ITS. Las parejas sexuales de los últimos tres meses del nuevo portador también deben ir a consulta, por seguridad.
Pasado este tiempo, la vida sexual del nuevo portador de ITS vuelve a la normalidad bajo ciertas precauciones. La primera, innegociable, es usar protección con métodos de barrera para no adquirir una nueva ITS o transmitir la infección a otra persona. La segunda es informarse correctamente sobre la ITS. La tercera es informar a las parejas sexuales de que padece una ITS y que eso implica mayor cuidado respecto a la protección.
Todo esto podemos evitarlo llevando una vida sexual llena de amor por nuestro cuerpo y el de nuestras parejas. El amor siempre implica protección.
Tipos de ITS según los síntomas
• Verrugas o úlceras: la aparición de úlceras sin ardor, dolor u olor pueden ser síntoma de sífilis primaria. Las úlceras dolorosas y con olor pueden ser síntoma de chancro. Las verrugas genitales pueden ser síntoma de VPH.
• Flujo o dolor: el flujo anormal (abundante y oloroso) tanto femenino como masculino puede ser síntoma de gonorrea, clamidia o tricomoniasis.
• Sin síntomas: algunas infecciones no producen cuadros característicos como lesiones, secreciones o dolor. La hepatitis y el VIH son ejemplos claros, y son difíciles de identificar en las primeras etapas sin exámenes.

![]()





Dejar un comentario